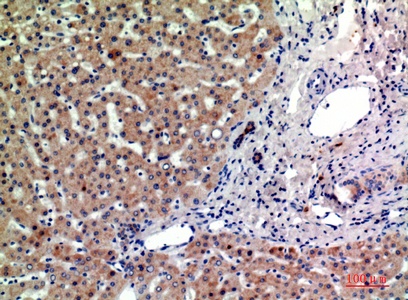
Fig.2. Immunohistochemical analysis of paraffin-embedded human-liver, antibody was diluted at 1:200.

| Product name | CD315 Polyclonal Antibody |
| Immunogen | Synthesized peptide derived from the Internal region of human CD315 |
| Host | Rabbit |
| Reactivity | Human,Mouse,Rat |
| Applications | WB,IHC,IF,ELISA |
| Applications notes | Optimal working dilutions should be determined experimentally by the investigator. Suggested starting dilutions are as follows: WB 1:500-1:2000;IHC: 1:100-300;ELISA 1:20000;IF 1:100-300;Not yet tested in other applications. |
| Clonality | Polyclonal |
| Preparation method | The antibody was affinity-purified from rabbit antiserum by affinity-chromatography using epitope-specific immunogen. |
| Alternative | PTGFRN; CD9P1; EWIF; FPRP; KIAA1436; Prostaglandin F2 receptor negative regulator; CD9 partner 1; CD9P-1; Glu-Trp-Ile EWI motif-containing protein F; EWI-F; Prostaglandin F2-alpha receptor regulatory protein; Prostaglandin F2-alpha receptor-associated protein |
| Formulation | Liquid solution |
| Concentration | 1 mg/ml |
| Molecular weight | 98kD |
| Storage buffer | Liquid in PBS containing 50% glycerol, 0.5% BSA and 0.02% sodium azide. |
| Storage instructions | Stable for one year at -20°C from date of shipment. For maximum recovery of product, centrifuge the original vial after thawing and prior to removing the cap. Aliquot to avoid repeated freezing and thawing. |
| Shipping | Gel pack with blue ice. |
| Precautions | The product listed herein is for research use only and is not intended for use in human or clinical diagnosis. Suggested applications of our products are not recommendations to use our products in violation of any patent or as a license. We cannot be responsible for patent infringements or other violations that may occur with the use of this product. |
| Background | Inhibits the binding of prostaglandin F2-alpha (PGF2-alpha) to its specific FP receptor, by decreasing the receptor number rather than the affinity constant. Functional coupling with the prostaglandin F3-alpha receptor seems to occur. |
| Gene ID | 5738 |
| Alternative | PTGFRN; CD9P1; EWIF; FPRP; KIAA1436; Prostaglandin F2 receptor negative regulator; CD9 partner 1; CD9P-1; Glu-Trp-Ile EWI motif-containing protein F; EWI-F; Prostaglandin F2-alpha receptor regulatory protein; Prostaglandin F2-alpha receptor-associated protein |
| Others | CD315 Polyclonal Antibody detects endogenous levels of CD315 protein. |
| Accession | Q9P2B2 |
| Observed Band(KD) | 98 |

Fig.1. Western Blot analysis of 293 cells using CD315 Polyclonal Antibody. Secondary antibody (catalog#: A21020) was diluted at 1:20000.
Fig.2. Immunohistochemical analysis of paraffin-embedded human-liver, antibody was diluted at 1:200.
You must be logged in to post a review.
Reviews
There are no reviews yet.